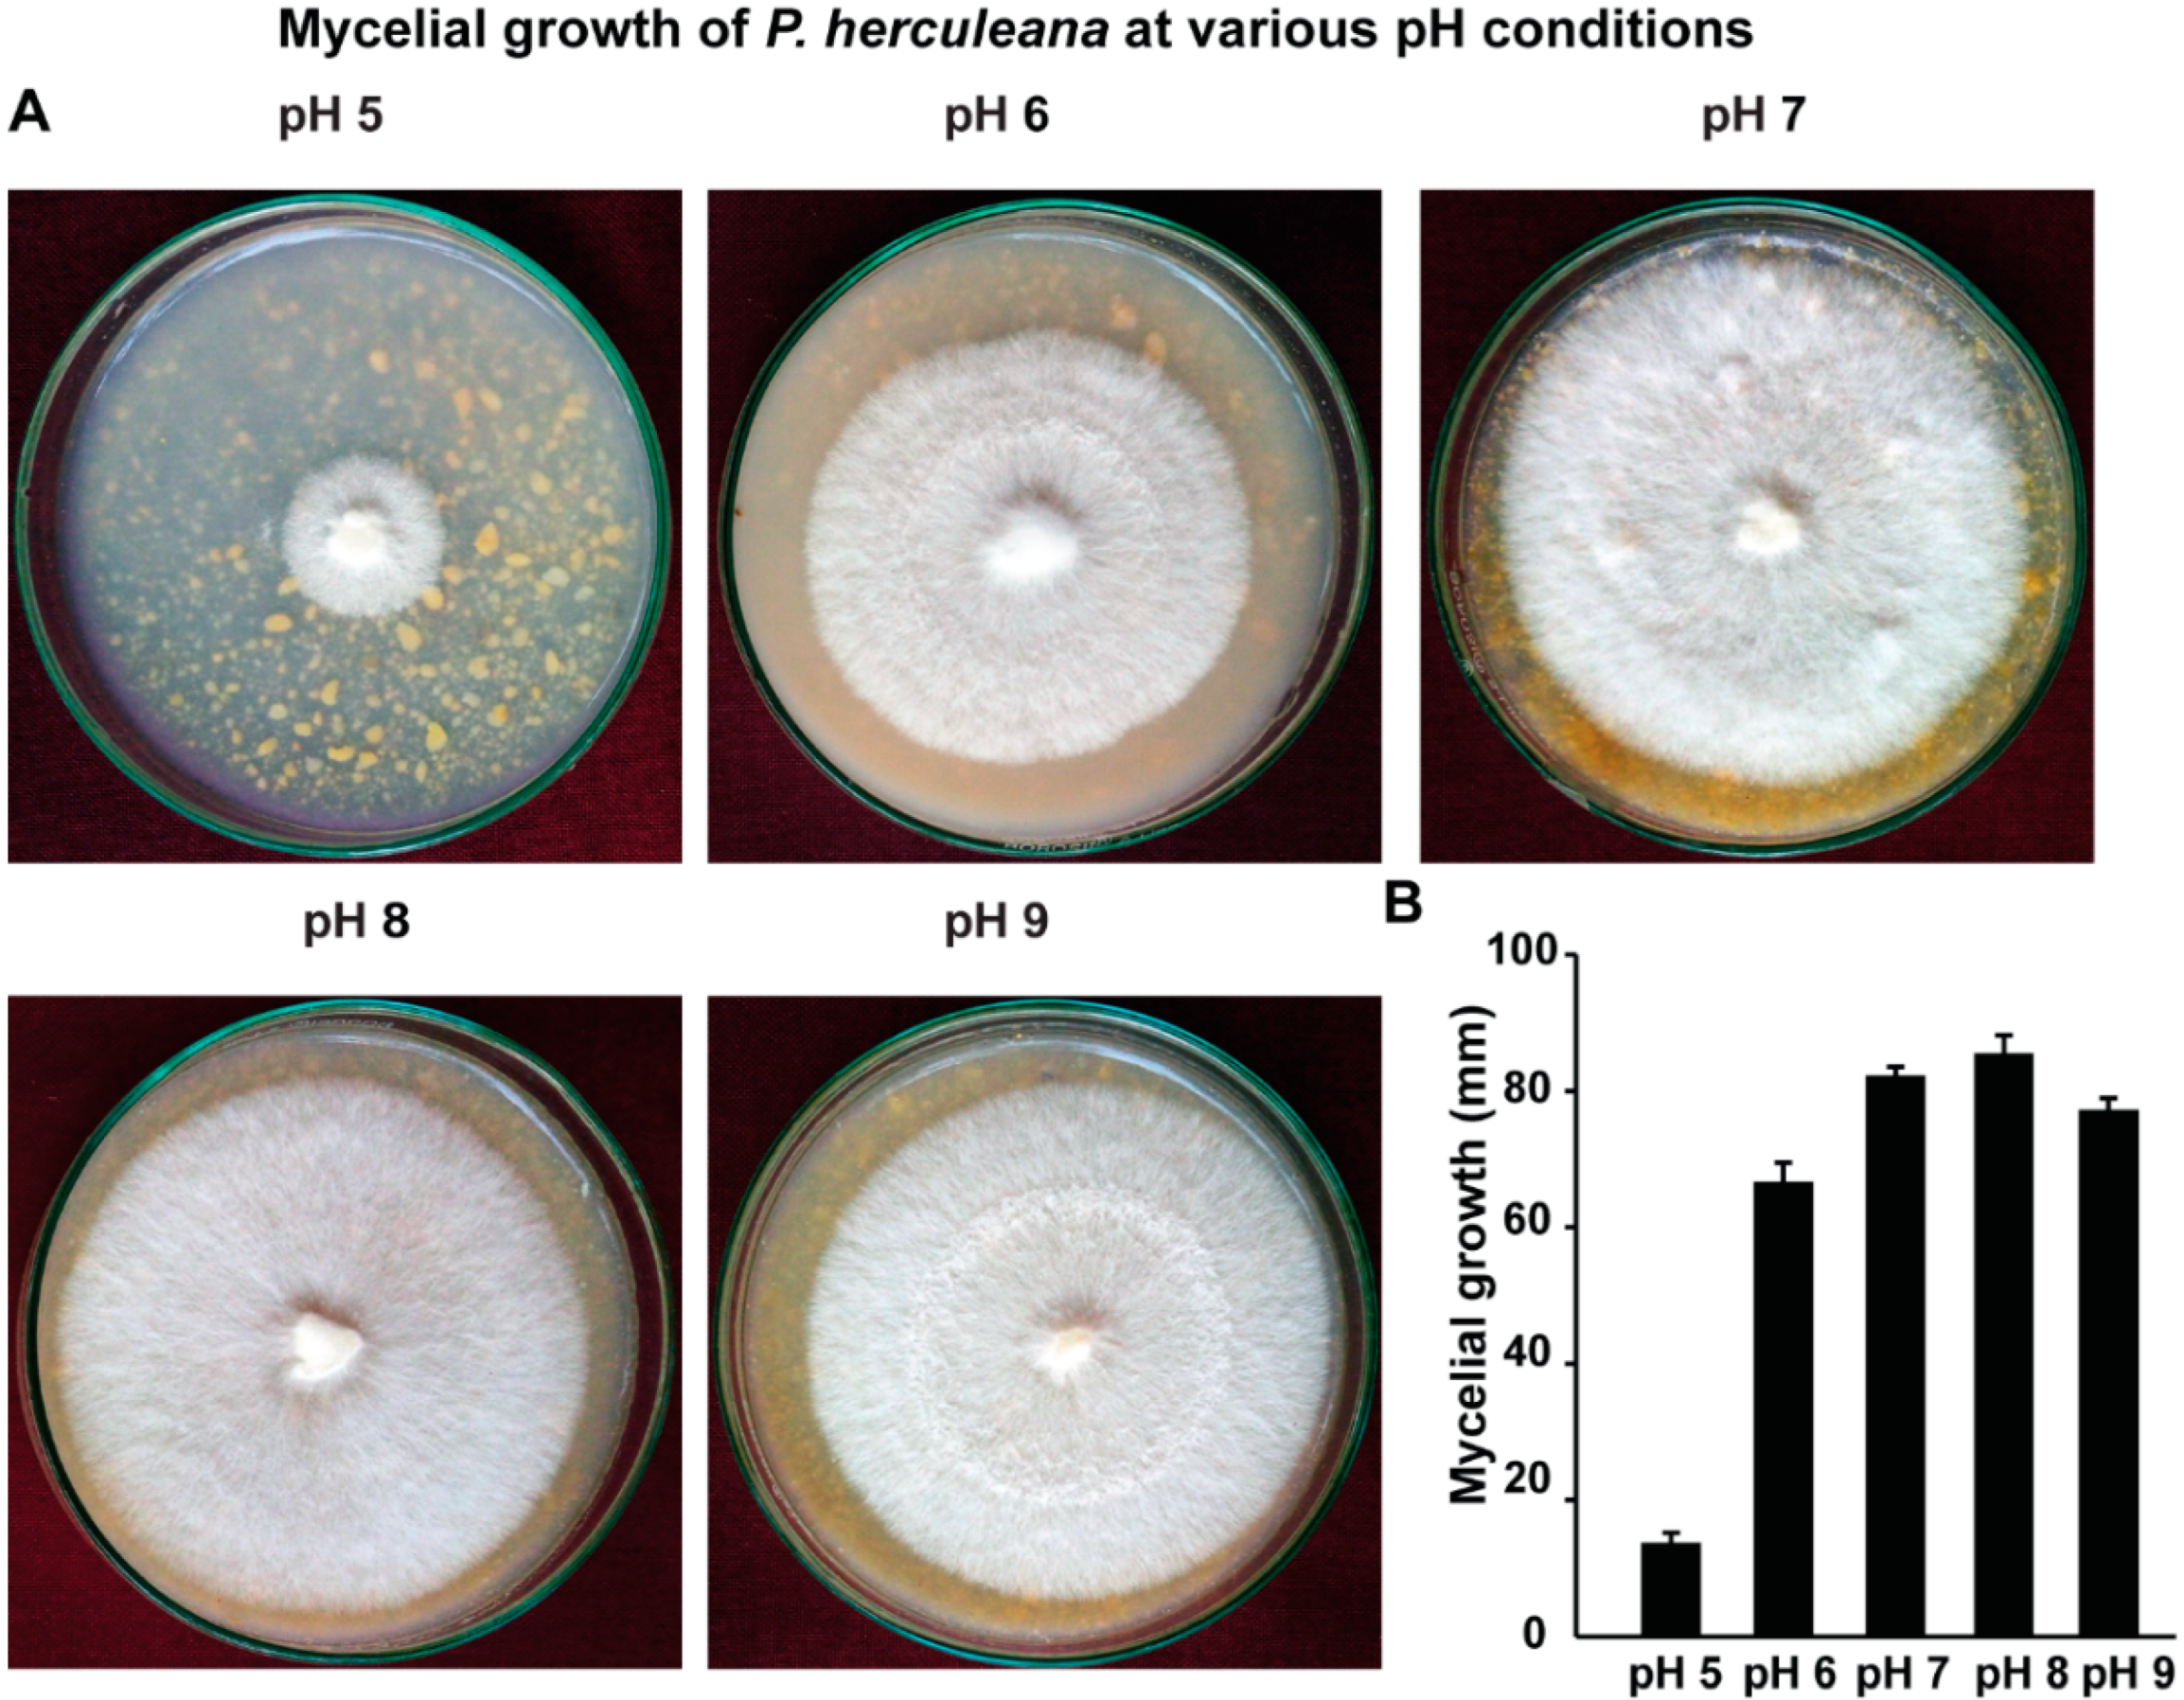
Processes 10 01797 g005 550

Studying Soil Ecology and Growth Conditions of Phellorinia herculeana, a Wild Edible Mushroom
Abstract
:1. Introduction
2. Materials and Methods
2.1. Survey, Edaphic Conditions, Isolation and Tissue Culture of P. herculeana
2.2. Assessment of Various Cereals and Pulse Grain-Based Agar Media for the Mycelial Growth of P. herculeana
2.3. Assessment of Various Concentration of Maize Grains and Glucose on the Mycelial Growth of P. herculeana
2.4. Assessment of Various Temperature Conditions on the Mycelial Growth of P. herculeana
2.5. Assessment of Various pH Conditions on the Mycelial Growth of P. herculeana
2.6. Assessment of Different Concentration Levels of Sand-Maize Medium
3. Results
3.1. Ecology and Edaphic Conditions of P. herculeana
3.2. P. herculeana Grows Well on Cereal Grains-Based Culture Media
3.3. P. herculeana Grows Well in Warm and Hot Temperature
3.4. P. herculeana Grows Well at Slightly Alkaline pH
3.5. P. herculeana Grows Well in Sand-Maize Medium at 19:1 Ratio Concentration
4. Discussion
5. Conclusions
Author Contributions
Funding
Institutional Review Board Statement
Informed Consent Statement
Data Availability Statement
Acknowledgments
Conflicts of Interest
References
- Kirk, P.M.; Cannon, P.F.; Minter, D.W.; Stalpers, J.A. Dictionary of the Fungi, 10th ed.; CAB International: Wallingford, UK, 2008; 771p. [Google Scholar]
- Bohra, B.; Doshi, A.; Sharma, S.S. Effect of different factors on the growth of Phellorinia inquinans. Micol. Ital. 2003, 32, 48–52. [Google Scholar]
- Dios, M.; Moreno, G.; Altés, A. Dictyocephalos attenuatus (Agaricales, Phelloriniaceae) new record from Argentina. Mycotaxon 2002, 84, 265–270. [Google Scholar]
- Gehlot, P.; Singh, S.K. Soil Characterization of Podaxis pistillaris and Phellorinia inquinanas natural growing sites in Indian Thar Desert. Indian J. Trop. Biodivers. 2015, 23, 82–84. [Google Scholar]
- Sharma, Y.K.; Doshi, A. Some studies on edible wild fungus Phellorinia inquinans in Rajasthan, India. Mushroom Res. 1996, 5, 51–53. [Google Scholar]
- Wright, J.E.; Moreno, G.; Altés, A. Dictyocephalos attenuatus (Agaricales, Phelloriniaceae) new for Europe. Cryptogam. Mycol. 1993, 14, 77–83. [Google Scholar]
- Manikandan, K.; Sharma, V.P.; Kumar, S.; Kamal, S.; Shirur, M. Edaphic conditions of natural sites of Morchella and Phellorinia. Mushroom Res. 2011, 20, 117–120. [Google Scholar]
- Panwar CH: Purohi, D.K. Antimicrobial activities of Podaxis pistillaris and Phellorinia inquinans against Pseudomonas aeruginosa and Proteus mirabilis. Mushroom Res. 2002, 11, 43–44. [Google Scholar]
- Al-Fatimi, M.; Wurster, M.; Kreisel, H.; Lindequist, U. Antimicrobial, cytotoxic and antioxidant activity of selected basidiomycetes from Yemen. Pharmazie 2005, 60, 776–780. [Google Scholar]
- Sobanbabu, G.; Reihana, R.; Parthiban, V.K.; Ramamoorthy, V. Molecular characterization of Phellorinia herculeana and optimization of nutrients for culturing in vitro. J. Mycol. Plant Pathol. 2018, 48, 444–451. [Google Scholar]
- Ramamoorthy, V.; Raguchander, T. Samiyappan, Enhanching resistance of tomato and hot pepper to pythium disease by seed treatment with fluorescent pseudomonads. Eur. J. Plant Pathol. 2002, 108, 429–441. [Google Scholar] [CrossRef]
- Conlon, B.H.; de Beer, Z.W.; De Fine Licht, H.H.; Aanen, D.K.; Poulsen, M. Phylogenetic analyses of Podaxis specimens from Southern Africa reveal hidden diversity and new insights into associations with termites. Fungal Biol. 2016, 120, 1065–1076. [Google Scholar] [CrossRef] [PubMed]
- Conlon, B.H.; Aanen, D.K.; Beemelmanns, C.; de Beer, Z.W.; De Fine Licht, H.H.; Gunde-Cimerman, N.; Schiøtt, M.; Poulsen, M. Reviewing the taxonomy of Podaxis: Opportunities for understanding extreme fungal lifestyles. Fungal Biol. 2019, 123, 183–187. [Google Scholar] [CrossRef] [PubMed]
- Praveen, G. Edible gastromycetes mushrooms of Thar dessert: New economic source for rural upliftment. Mushroom Res. 2016, 25, 55–56. [Google Scholar]
- Singh, S.K.; Doshi, A.; Yadav, M.C.; Kamal, S. Molecular characterization of speciality mushrooms of western Rajasthan, India. Curr. Sci. 2006, 91, 1225–1230. [Google Scholar]
- Conlon, B.H.; Gostinčar, C.; Fricke, J.; Kreuzenbeck, N.B.; Daniel, J.M.; Schlosser, M.S.L.; Peereboom, N.; Aanen, D.K.; de Beer, Z.W.; Beemelmanns, C.; et al. Genome reduction and relaxed selection is associated with the transition to symbiosis in the basidiomycete genus Podaxis. iScience 2021, 24, 102680. [Google Scholar] [CrossRef] [PubMed]
- Fuhrer, B. A Field Guide to Australian Fungi; Blooming Books Pty Ltd.: Melbourne, Australia, 2005. [Google Scholar]
- Yousaf, N.; Niazi, A.R.; Khalid, A.N. New records of noteworthy gasteroid fungi from Pakistan. Mycotaxon 2012, 119, 261–267. [Google Scholar] [CrossRef]
- Nam, G.A.; Rakhimova, Y.V. New location of rare macromycetes (Cerioporus rhizophilus, Galeropsis desertorum and Phellorinia herculeana) in Kazakhstan. Curr. Res. Environ. Appl. Mycol. 2017, 7, 301–308. [Google Scholar] [CrossRef]
- Kreisel, H.; Al-Fatimi, M. Basidiomycetes and larger Ascomycetes from Yemen. Feddes Repert. 2004, 115, 547–561. [Google Scholar] [CrossRef]
- Sharma, V.P.; Singh, M.; Satish, K.; Kamal, S.; Singh, R. Phylogeny and physiology of Phellorinia spp.: A delicacy of Indian Desert. Phellorinia. Int. Res. J. Nat. Appl. Sci. 2015, 2, 1–17. [Google Scholar]
- Rathore, H.; Prasad, S.; Sharma, S. Mushroom nutraceuticals for improved nutrition and better human health: A review. Pharma Nutr. 2017, 5, 35–46. [Google Scholar] [CrossRef]
- Ramamoorthy, V.; Shantappa, S.; Dhingra, S.; Calvo, A.M. veA-dependent RNA-pol II transcription elongation factor-like protein, RtfA, is associated with secondary metabolism and morphological development in Aspergillus nidulans. Mol. Microbiol. 2012, 85, 795–814. [Google Scholar] [CrossRef] [PubMed]
- Feng, X.; Ramamoorthy, V.; Pandit, S.S.; Prieto, A.; Espeso, E.A.; Calvo, A.M. cpsA regulates mycotoxin production, morphogenesis and cell wall biosynthesis in the fungus Aspergillus nidulans. Mol. Microbiol. 2017, 105, 1–24. [Google Scholar] [CrossRef] [PubMed] [Green Version]
- Jayalakshmi, R.; Oviya, R.; Premalatha, K.; Mehetre, S.T.; Paramasivam, M.; Kannan, R.; Theradimani, M.; Pallavi, M.S.; Mukherjee, P.K.; Ramamoorthy, V. Production, stability and degradation of Trichoderma gliotoxin in growth medium, irrigation water and agricultural soil. Sci. Rep. 2021, 11, 16536. [Google Scholar] [CrossRef] [PubMed]

Publisher’s Note: MDPI stays neutral with regard to jurisdictional claims in published maps and institutional affiliations. |
© 2022 by the authors. Licensee MDPI, Basel, Switzerland. This article is an open access article distributed under the terms and conditions of the Creative Commons Attribution (CC BY) license (https://creativecommons.org/licenses/by/4.0/).
Share and Cite
Oviya, R.; Sobanbabu, G.; Anbazhagan, P.; Revathy, N.; Mahalakshmi, P.; Manonmani, K.; Mareeswari, P.; Vijayasamundeeswari, A.; Shanmugaiah, V.; Mehetre, S.; et al. Studying Soil Ecology and Growth Conditions of Phellorinia herculeana, a Wild Edible Mushroom. Processes 2022, 10, 1797. https://doi.org/10.3390/pr10091797
Oviya R, Sobanbabu G, Anbazhagan P, Revathy N, Mahalakshmi P, Manonmani K, Mareeswari P, Vijayasamundeeswari A, Shanmugaiah V, Mehetre S, et al. Studying Soil Ecology and Growth Conditions of Phellorinia herculeana, a Wild Edible Mushroom. Processes. 2022; 10(9):1797. https://doi.org/10.3390/pr10091797
Chicago/Turabian StyleOviya, Rajendiran, Gunasekaran Sobanbabu, Palaniappan Anbazhagan, Natarajan Revathy, Palani Mahalakshmi, Karunakaran Manonmani, Petchimuthu Mareeswari, Ayyathurai Vijayasamundeeswari, Vellasamy Shanmugaiah, Sayaji Mehetre, and et al. 2022. "Studying Soil Ecology and Growth Conditions of Phellorinia herculeana, a Wild Edible Mushroom" Processes 10, no. 9: 1797. https://doi.org/10.3390/pr10091797
APA StyleOviya, R., Sobanbabu, G., Anbazhagan, P., Revathy, N., Mahalakshmi, P., Manonmani, K., Mareeswari, P., Vijayasamundeeswari, A., Shanmugaiah, V., Mehetre, S., & Ramamoorthy, V. (2022). Studying Soil Ecology and Growth Conditions of Phellorinia herculeana, a Wild Edible Mushroom. Processes, 10(9), 1797. https://doi.org/10.3390/pr10091797

